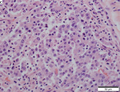

Colorectal adenocarcinoma
| Colorectal adenocarcinoma | |
|---|---|
| Diagnosis in short | |
 Colorectal adenocarcinoma. H&E stain. | |
| LM DDx | other adenocarcinomas (e.g. anal gland adenocarcinoma, lung adenocarcinoma, ovarian adenocarcinoma), traditional adenoma esp. with high-grade dysplasia, sessile serrated adenoma with dysplasia |
| IHC | CK20 +ve, CDX2 +ve, CK7 -ve, beta-catenin (nuclear) +ve |
| Grossing notes | lower anterior resection for cancer grossing, other protocols |
| Staging | colorectal cancer staging |
| Site | rectum, colon, cecum, appendix |
|
| |
| Associated Dx | long standing IBD (Crohn's disease, ulcerative colitis), traditional adenoma esp. with high-grade dysplasia, sessile serrated adenoma esp. with dysplasia |
| Syndromes | familial adenomatous polyposis, Lynch syndrome, Peutz-Jeghers syndrome, Juvenile polyposis syndrome, serrated polyposis syndrome, MUTYH polyposis syndrome, Cowden syndrome |
|
| |
| Signs | +/-blood in stools, +/-abdominal mass, +/-rectal mass, +/-signs of bowel obstruction (nausea, vomiting), +/-narrow caliber stools |
| Symptoms | +/-constipation |
| Prevalence | common |
| Blood work | +/-anemia (microcytic), +/-CEA elevated |
| Radiology | +/-"apple core" lesion (classic), +/-findings of bowel obstruction (air-fluid levels esp. with transition point) |
| Endoscopy | +/-suspicious mass (exophytic or ulcerated), presence of non-lifting sign, Kudo pit pattern Type VI or Type VN |
| Prognosis | good to poor |
| Other | fecal occult blood test (FOBT) +ve |
| Clin. DDx | colorectal tumours, other causes - DDx dependent on presentation |
| Treatment | usually surgical resection +/-chemotherapy +/-radiation |
Colorectal adenocarcinoma is very common, a leading cause of death due to cancer, and the most common form of colon cancer.
The colon and rectum are lumped together as the mucosa in the large bowel is very similar. Thus, colonic adenocarcinoma and rectal adenocarcinoma redirect to this article.
The larger generally topic of colorectal tumours and the pathogenesis of colorectal adenocarcinoma is dealt with in the colorectal tumours article.
Colorectal carcinoma, abbreviated CRC, is typically considered a synonym. Cecal adenocarcinoma is also lumped into CRC.
General
- Very common.
- Rectum and sigmoid > proximal large bowel.
Presentation:
- Bright red blood per rectum (BRBPR).
- Constipation.
- Symptoms of bowel obstruction - nausea, vomiting.
- Weight loss.
Pathogenesis - see pathogenesis of colorectal carcinoma.
Clinical - serum:
- CEA elevated.[1]
- CA19-9 elevated.
- Colon cancer-specific antigen-2 (CCSA-2) elevated.[2]
- Relatively new; preliminary in 2014.
Gross
Often circumferential or near circumferential:
- These are referred to as "apple core lesion" or "napkin-ring" lesion.
Mucosa:
- Granular appearance.
- Raised (exophytic) or heaped edges with ulceration.
Note:
- Total mesorectal excisions should be assessed for completeness.
- The (soft tissue) radial margins, as present in TMEs and right hemicolectomies, should be inked.[3][4]
Images
Microscopic
Features:
- Nuclear atypia:
- Nuclear pseudostratification.
- Nuclear hyperchromasia.
- Chromatin clearing or granularity.
- +/-Necrosis.
- Architecture - important for grading:
- Glands.
- Sheets.
DDx:
- Other adenocarcinomas (e.g. anal gland adenocarcinoma, lung adenocarcinoma, ovarian adenocarcinoma, ductal adenocarcinoma of the prostate).
- Traditional adenoma esp. with high-grade dysplasia.
- Sessile serrated adenoma with dysplasia.
Images
Mucinous adenocarcinoma - very low mag. (WC/Nephron)
CRC lymph node metastasis. (WC/Nephron)
Medullary carcinoma of cecum of elderly woman. A. Tumor extends from the luminal surface at upper left into the muscularis propria at lower right. Note variable longitudinal spaces in the tumor. B. Tumor extends into pericolic fat. Note relative circumscription, with pushing borders. C. Tumor cells, often in seeming syncitiums, strew lymphocytes. D. In other areas, there appears to be a pattern suggesting nests and stromal trabeculums. Chromogranin/synaptophysin were negative.
www:
Grading
8th edition of AJCC - based on component composed of glands:
- Grade 1: >95% of tumour = well-differentiated.
- Grade 2: >=50-95% of tumour = moderately differentiated.
- Grade 3: <50% of tumour = poorly-differentiated.
- Grade 4: 0% glandular, no mucin, no squamous differentiation = undifferentiated.
Old system
Based on component composed of glands:
- >=50% of tumour = low-grade (well-differentiated and moderately differentiated).
- <50% of tumour = high-grade (poorly-differentiated and undifferentiated).
Peritumoural lymphocytic response
Intratumoural lymphocytic response
- AKA tumour-infiltrating lymphocytes, abbreviated TILs.
Tumour deposits
Tumour regression
There is a three tiered regression grading system by Ryan et al. for colorectal cancer that has essentially been adopted by CAP:[7]
| Grade | Features |
|---|---|
| Grade 1 | small groups of tumour cells or single tumour cells |
| Grade 2 | definite tumour but more fibrosis ("cancer outgrown by fibrosis") |
| Grade 3 | definite tumour with no fibrosis or tumour with a lesser amount of fibrosis ("fibrosis outgrown by cancer") |
IHC
- CK7 -ve. ‡
- CK20 +ve.
- CEA +ve.
- CDX2 +ve.
Note:
- ‡ High stage colorectal cancer (CRC) may be CK7 +ve/CK20 +ve; in one series, 13% of stage 3 and 17% of stage 4 colorectal cancers were CK7 +ve/CK20 +ve.[8]
Molecular
- KRAS mutation analysis.
- Mutation present ~ 40% of CRC.
- Mutations in codons 12 or 13 associated with failure of anti-EGFR therapy (e.g. cetuximab, panitumumab).[9]
- BRAF mutation analysis.
- V600E missense mutation found in ~10% CRC.[10]
- Microsatellite instability - see microsatellite instability in colorectal cancer.
Note:
- KRAS mutations and BRAF mutations are considered mutually exclusive as they occur in the same pathway.
Sign out
Right hemicolectomy
TERMINAL ILEUM, CECUM, ASCENDING COLON AND APPENDIX, RIGHT HEMICOLECTOMY: - INVASIVE ADENOCARCINOMA, LOW-GRADE, pT2, pN0. -- MARGINS NEGATIVE FOR DYSPLASIA AND NEGATIVE FOR MALIGNANCY. -- PLEASE SEE TUMOUR SUMMARY. - SMALL BOWEL WALL WITHIN NORMAL LIMITS. - APPENDIX WITHOUT SIGNIFICANT PATHOLOGY. - TWELVE LYMPH NODES NEGATIVE FOR MALIGNANCY ( 0 POSITIVE / 12 ).
Mucinous component present
TERMINAL ILEUM, CECUM, ASCENDING COLON AND APPENDIX, RIGHT HEMICOLECTOMY: - INVASIVE ADENOCARCINOMA WITH A MUCINOUS COMPONENT, LOW-GRADE, pT1, pN0. -- MARGINS NEGATIVE FOR DYSPLASIA AND NEGATIVE FOR MALIGNANCY. -- PLEASE SEE TUMOUR SUMMARY. - SMALL BOWEL WALL WITHIN NORMAL LIMITS. - APPENDIX WITHOUT SIGNIFICANT PATHOLOGY. - FOURTEEN LYMPH NODES NEGATIVE FOR MALIGNANCY ( 0 POSITIVE / 14 ).
Left hemicolectomy
LEFT COLON, LEFT HEMICOLECTOMY: - INVASIVE ADENOCARCINOMA, LOW-GRADE, pT1, pN0. -- MARGINS NEGATIVE FOR DYSPLASIA AND NEGATIVE FOR MALIGNANCY. -- TWELVE LYMPH NODES NEGATIVE FOR MALIGNANCY ( 0 POSITIVE / 12 ). -- PLEASE SEE TUMOUR SUMMARY.
Biomarker and molecular testing
The Colorectal Cancer Panel (BRAF, KRAS, NRAS, PIK3CA, PTEN) was ordered on block {}. MMR testing was ordered on block {}.
See also
References
- ↑ Bagaria, B.; Sood, S.; Sharma, R.; Lalwani, S. (Sep 2013). "Comparative study of CEA and CA19-9 in esophageal, gastric and colon cancers individually and in combination (ROC curve analysis).". Cancer Biol Med 10 (3): 148-57. doi:10.7497/j.issn.2095-3941.2013.03.005. PMID 24379990.
- ↑ Xue, G.; Wang, X.; Yang, Y.; Liu, D.; Cheng, Y.; Zhou, J.; Cao, Y. (2014). "Colon cancer-specific antigen-2 may be used as a detecting and prognostic marker in colorectal cancer: a preliminary observation.". PLoS One 9 (4): e94252. doi:10.1371/journal.pone.0094252. PMID 24710115.
- ↑ URL: http://www.cancercare.on.ca/common/pages/UserFile.aspx?fileId=13954. Accessed on: 6 February 2013.
- ↑ Bateman, AC.; Carr, NJ.; Warren, BF. (Apr 2005). "The retroperitoneal surface in distal caecal and proximal ascending colon carcinoma: the Cinderella surgical margin?". J Clin Pathol 58 (4): 426-8. doi:10.1136/jcp.2004.019802. PMID 15790712.
- ↑ Ogino, S.; Nosho, K.; Irahara, N.; Meyerhardt, JA.; Baba, Y.; Shima, K.; Glickman, JN.; Ferrone, CR. et al. (Oct 2009). "Lymphocytic reaction to colorectal cancer is associated with longer survival, independent of lymph node count, microsatellite instability, and CpG island methylator phenotype.". Clin Cancer Res 15 (20): 6412-20. doi:10.1158/1078-0432.CCR-09-1438. PMID 19825961.
- ↑ URL: http://www.cap.org/apps/docs/committees/cancer/cancer_protocols/2012/Colon_12protocol_3200.pdf. Accessed on: 14 September 2012.
- ↑ Ryan, R.; Gibbons, D.; Hyland, JM.; Treanor, D.; White, A.; Mulcahy, HE.; O'Donoghue, DP.; Moriarty, M. et al. (Aug 2005). "Pathological response following long-course neoadjuvant chemoradiotherapy for locally advanced rectal cancer.". Histopathology 47 (2): 141-6. doi:10.1111/j.1365-2559.2005.02176.x. PMID 16045774.
- ↑ Hernandez, BY.; Frierson, HF.; Moskaluk, CA.; Li, YJ.; Clegg, L.; Cote, TR.; McCusker, ME.; Hankey, BF. et al. (Mar 2005). "CK20 and CK7 protein expression in colorectal cancer: demonstration of the utility of a population-based tissue microarray.". Hum Pathol 36 (3): 275-81. doi:10.1016/j.humpath.2005.01.013. PMID 15791572.
- ↑ Monzon, FA.; Ogino, S.; Hammond, ME.; Halling, KC.; Bloom, KJ.; Nikiforova, MN. (Oct 2009). "The role of KRAS mutation testing in the management of patients with metastatic colorectal cancer.". Arch Pathol Lab Med 133 (10): 1600-6. doi:10.1043/1543-2165-133.10.1600. PMID 19792050.
- ↑ Tie J, Gibbs P, Lipton L, et al. (July 2010). "Optimizing targeted therapeutic development: Analysis of a colorectal cancer patient population with the BRAF(V600E) mutation". Int J Cancer. doi:10.1002/ijc.25555. PMID 20635392.